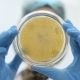
Microbiology Laboratory Work, Petri Dish - VideoHive Item for Sale

-
2 Sales $10
-
1 Sale $10
-
3 Sales $27
-
1 Sale $10
-
0 Sales $10
-
2 Sales $23
-
0 Sales $10
-
4 Sales $27
-
0 Sales $23
-
1 Sale $8
-
1 Sale $8
-
1 Sale $8
-
21 Sales $27
Your all-in-one creative subscription
Subscribe to Envato Elements.